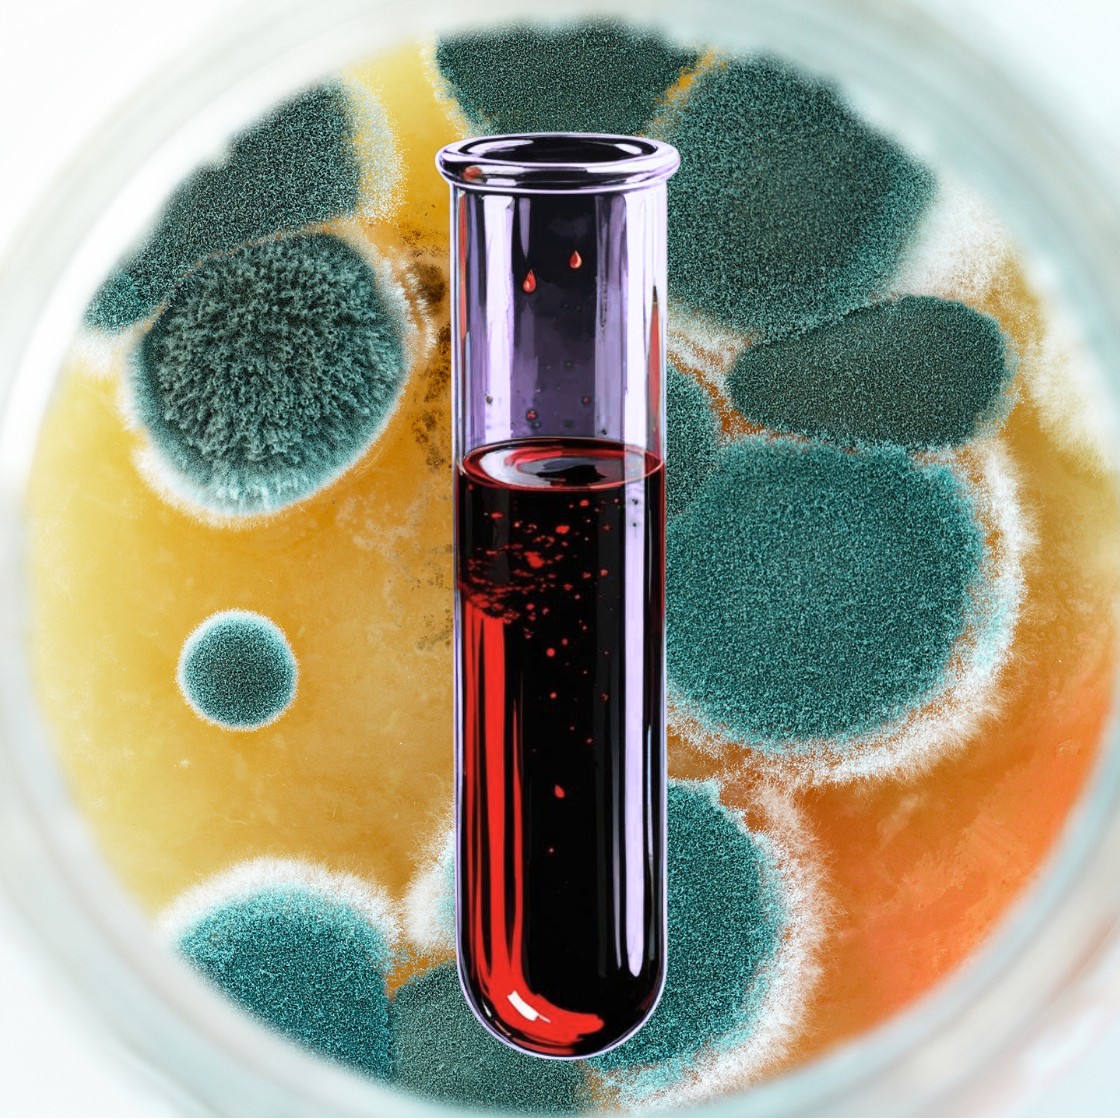

Badanie pozwalające wykryć alergię na Cladosporium herbarum
(alergen pleśniowy) typu pierwszego.
Badanie na Cladosporium herbarum jest badaniem alergologicznym z krwi. Badanie na alergię na Cladosporium oznacza alergen pleśniowy.
Badanie polega na oznaczeniu przeciwciał IgE we krwi i jest wykonywane w przypadku podejrzenia uczulenia na Cladosporium. Zaletą badania jest brak konieczności odstawienia leków przeciwhistaminowych. Badanie alergenów z krwi wykorzystywane jest również do kwalifikacji do odczulania alergii na pleśń.
Polecane jest również do diagnozy czynników alergizujących u dzieci poniżej 4 roku życia.